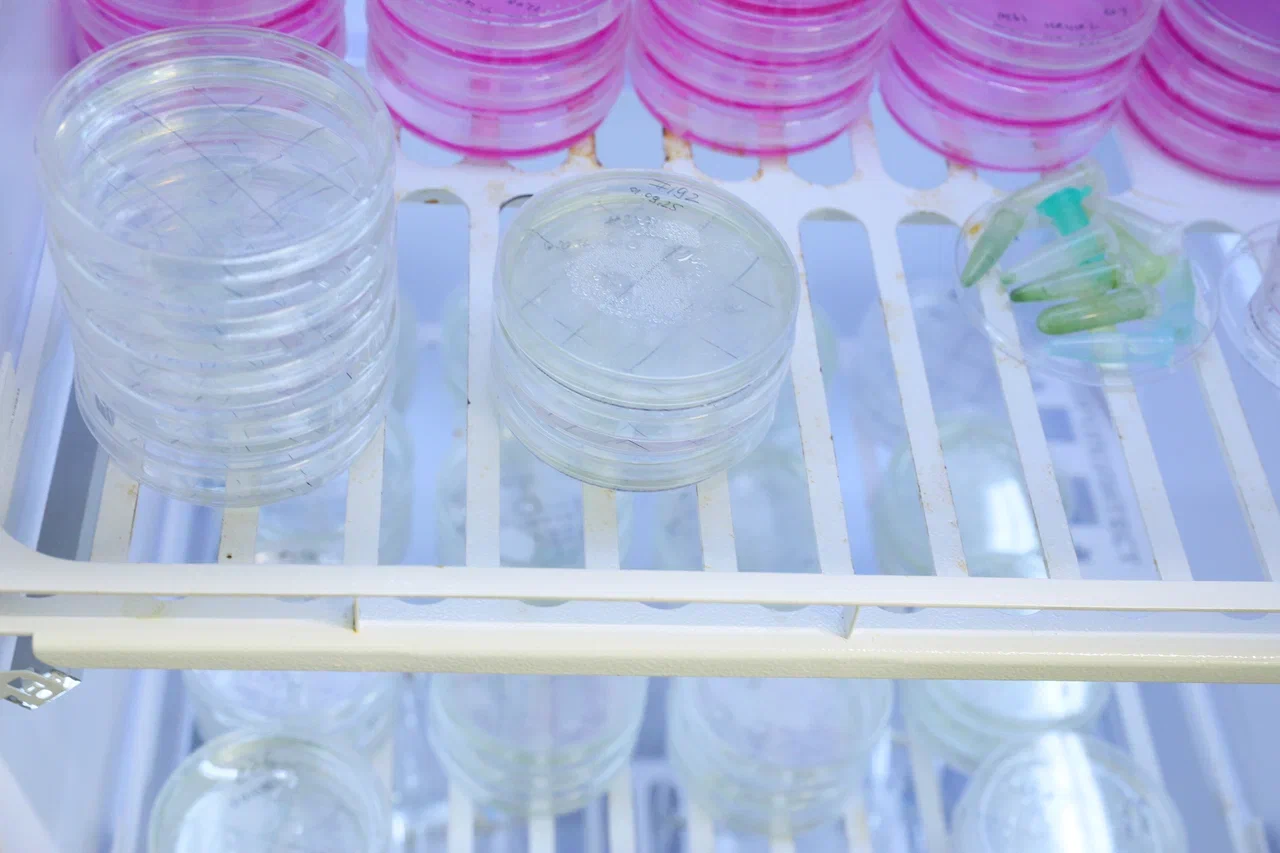
Фото Николая Малахина/портал "Научная Россия".

Человек VS трихоплакс: так ли мало у нас общего?
Привет, дорогой читатель! Представь: ты заходишь в здание, где в каждой лаборатории бьется ключом научная мысль, пытающаяся расшифровать главную загадку природы — наш собственный мозг. Именно так себя ощутили участники студенческого пресс-тура в Институт высшей нервной деятельности и нейрофизиологии (ИВНД и НФ) РАН.

Лаборатория клеточной биологии обучения. Совсем юная девушка, похожая на студентку, выступает с лекцией у электронной доски. Как оказалось, перед нами опытный специалист – Дарья Юрьевна Романова, кандидат биологических наук, научный сотрудник лаборатории клеточной нейробиологии обучения ИВНД и НФ РАН, руководитель проекта РНФ «Геномные и клеточные основы поведения у безнервных животных». Проект Дарьи и ее коллег посвящен исследованию клеточных и молекулярных основ поведения у трихоплаксов – очень древних многоклеточных, доживших до наших дней. Ученым, как и нам с вами, стало безумно интересно: какие механизмы позволяют простейшему животному проявлять сложные реакции без мозга и нейронов.
— По разным оценкам, нейрон сам по себе, как клетка, возникал несколько раз в процессе эволюции у разных типов животных. У нас не было единственного далекого предка, от которого все живые организмы получили нейроны. Этих событий, по данным различных групп ученых, происходило от 9 до 16, — подчеркивает Дарья Юрьевна.

Трихоплаксы не обладают не только нервной системой, но и мышцами, скелетом и пр. У них всего лишь порядка 10 клеточных типов, расположенных в три слоя. Живут при этом они порядка полумиллиарда лет и в, принципе, считаются бессмертной клоновой линией при поддержке надлежащих условий жизнедеятельности. Дарья Юрьевна и ее коллеги считают, что нервная система у трихоплакса не появилась потому, что она ему не нужна: все необходимые реакции и даже сложное поведение животных регулируются через секрецию или через волокнистые клетки – предшественников появления нейронов. Пластинчатые как раз и интересны науке тем, что стали ключом к разгадке появления нейронов, мозга и принципов их работы.

Дарья Юрьевна подробно рассказала студентам о сложных формах поведения трихоплаксов, бросающих вызов их примитивному строению. Оказалось, что эти простейшие животные демонстрируют не просто реакции на раздражители вроде света или тепла, разнообразие траекторий движения, уход от механического раздражителя с определением его направления, а целый спектр стратегических моделей. Одним из ярких примеров является сложное социальное пищевое поведение. Когда пищи в избытке, трихоплаксы, размножившиеся вегетативно, не расходятся, а формируют агрегации. Это коллективное действие имеет четкую цель — энергоэффективность. Находясь в группе, они совместно выделяют больше пищеварительных ферментов в субстрат, что позволяет эффективнее перерабатывать пищу и делиться ею, поддерживая жизнедеятельность всей «колонии». Если же еды недостаточно, трихоплакс предпочитает уменьшить площадь своего тела, но не пойти на поглощение или уничтожение организмов своего вида, что может расцениваться, как элемент альтруизма.

Еще более удивителен элемент заботы о потомстве. Помимо обычного вегетативного деления, у трихоплаксов иногда образуются мелкие «бродяжки», имитирующие элементы полового размножения, несмотря на наличие у одной особи как мужских, так и женских генов. Учёные наблюдали, как материнская особь может какое-то время «накрывать» собой такую дочернюю, перемещаясь вместе с ней. Это не просто пассивное сосуществование — исследователи предполагают, что это форма защиты, а возможно, даже примитивный процесс обучения, когда родитель «знакомит» потомство с окружающей средой.
— Наконец, трихоплаксы обладают развитой стратегией иммунной защиты. Это не аутоиммунный ответ на клеточном уровне, а целенаправленное поведение. Чтобы справиться с вышедшими из-под контроля симбиотическими бактериями, животное инкапсулирует патогены в специальную сферу в верхнем слое тела и целенаправленно выбрасывает их во внешнюю среду, демонстрируя сложный алгоритм защиты от угрозы, — поведала студентам Дарья Романова.

При всех своих эволюционных преимуществах, трихоплаксы смертны. Погибнуть они могут от некорректных условий содержания – например, загрязнения морской воды – естественной среды их обитания, лишения трихоплаксов питания и пр. Ученые стараются заботиться о своих подопечных: регулируют температуру и влажность в камерах, готовят искусственную морскую воду. Александр Алексеевич Повернов, аспирант, лаборант лаборатории клеточной нейробиологии обучения показывает нам под микроскопом живые культуры трихоплаксов в чашках Петри и рассказывает о том, как антибиотики влияют на поведение этих реликтовых животных.
— Трихоплаксы ампициллиновой линии, то есть те, в отношении которых применялись антибиотики, дольше увеличиваются в числе и дольше вырастают, но более устойчивы ко внешним воздействиям. Когда животные обычной линии начинают уменьшаться в количестве после того, как в чашке Петри накапливается достаточно вредных веществ, численность животных ампициллиновой линии сохраняется на протяжении более длительного времени, — отмечает Александр Алексеевич.

Другой эксперимент над трихоплаксами заключается в добавлении к водорослям нескольких рисинок, выделяющих в среду свои вещества при разложении. Животные рисовой линии, напротив, гораздо быстрее обычных размножаются и растут. Если в нормальной чашке Петри животных от 80 до 100, то в рисовой – 200-300 животных, однако, этот рост быстро прекращается, и через две недели число животных идет на спад и уменьшается до 20-30 организмов. При пересадке животных на новую чашку снова наблюдается быстрый рост. Животные рисовой, обычной и ампициллиновой линии различаются на уровне транскриптома, то есть набора всех транскриптов РНК, включая кодирующие и некодирующие, в индивидууме или популяции клеток, поэтому при исследованиях, исключая сравнительный анализ, используется только какая-то одна линия.

— Микроскоп открывает вам уникальное строение трихоплакса: несмотря на всего три клеточных слоя и десяток типов клеток, животные способны на сложную координацию. Главное же — вы приоткроете завесу тайны над их «клеточным интеллектом». Вы наглядно понимаете, как клетки общаются посредством пептидов и кальциевых сигналов, создавая нечто вроде памяти — например, способность «запомнить» химический след хищника. Знакомство с трихоплаксом — возможность увидеть самую раннюю стадию эволюции поведения и фундаментальные механизмы, общие для всех животных, и для нас с вами в том числе, — заключил Александр Повернов.

Научная ценность исследования трихоплаксов для человека заключается не в прямом медицинском или экономическом применении, а в фундаментальном понимании ключевых биологических принципов, которые универсальны для всего животного мира, включая нас самих, однако изучение закономерностей сложного поведения этих животных в перспективе может послужить основой для создания «синтетического мозга». Эта задача особенно актуальна в эпоху цифровизации и очень быстрого развития искусственного интеллекта. Помимо прочего, изучение «прото-нервной» системы трихоплаксов, их клеточной коммуникации и регенеративных способностей может в будущем подсказать новые подходы в лечении нейродегенеративных заболеваний или в регенеративной медицине, а также в лечении аутоимунных заболеваний.

— Нобелевская ассамблея Каролинского института в Стокгольме неслучайно объявила, что премию по физиологии или медицине в 2025 году решили присудить американцам Мэри Брунков (Институт системной биологии, расположенный в Сиэтле) и Фрэду Рамсделлу (Институт иммунотерапии рака Паркера в Сан-Франциско), а также Шимону Сакагучи, профессору Университета Осаки (Япония). Так отметили их исследования в области иммунитета: «за новаторские открытия, касающиеся периферической иммунологической толерантности, которая предотвращает нанесение вреда организму со стороны иммунной системы», — рассказала нашей редакции Любовь Петровна Николаева, кандидат биологических наук, доцент Российского нового университета. – Лауреаты этого года выявили регуляторные Т-клетки (центральные регуляторы иммунного ответа), предотвращающие атаку иммунных клеток на собственный организм. Если знать, работа какого белка «срывается с катушек», и организм начинает себя «поедать», можно понять, каким образом можно предотвратить возникновение и развитие аутоимунных и онкологических заболеваний.

По словам Любови Петровны, у трихоплаксов были найдены гены, встречающиеся у высших животных, включая человека. Эти гены можно секвенировать, а, поскольку трихоплакс – простейшее животное, которое быстро размножается, их можно использовать для лечения людей с аутоимунными заболеваниями. В настоящее время генетики всего мира интенсивно исследуют трихоплакса, поскольку в перспективе результаты их наработок могут оказаться полезными в разработке препаратов, позволяющих полностью излечить аутоимунное заболевание, а не только вывести пациента в ремиссию на время.

Автор: alyonayurchenko

